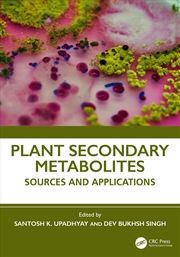
Buy Plants Secondary Metabolites Sources And Applications

Relax this Easter with a great book from our range of books on sale at Sanity. From bestselling fiction to inspiring non-fiction, there’s something for every reader.
Perfect for quiet moments or thoughtful Easter gifts, discover new favourites and great reads for the long weekend.

 |
Help you find exactly what you are looking for, even if you aren't sure yourself! |
 |
Track down the hard to find as quickly as possible - if it's available, we will get it! |
 |
Deliver fast and friendly service to every customer. |
 |
Provide you with the hottest, the latest and a great range. |
 |
And if you're not satisified, you can exchange or with a receipt, get your money back - no questions asked! |